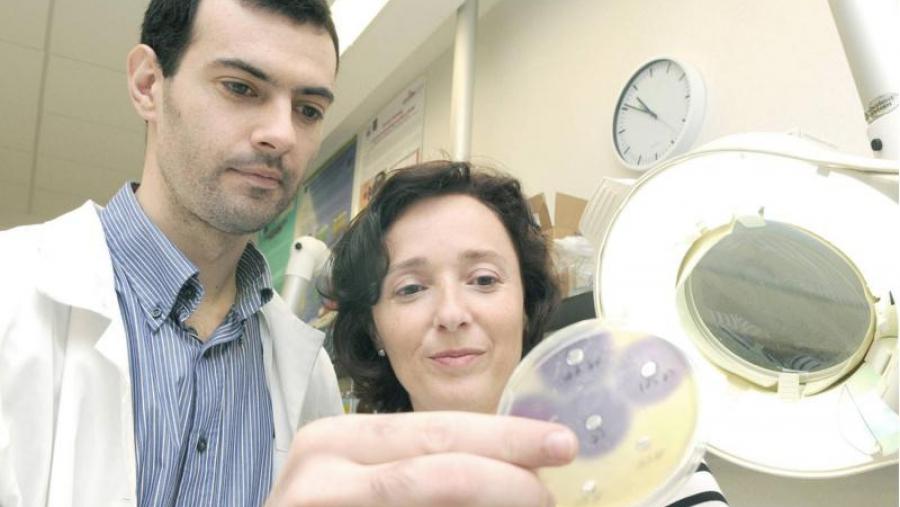
Investigadores da USC avanzan nun mecanismo alternativo aos antibióticos co que tratar infeccións acuícolas

Investigadores da USC avanzan nun mecanismo alternativo aos antibióticos co que tratar infeccións acuícolas
Un grupo de investigadores do Departamento de Microbioloxía da USC logrou illar diversas bacterias mariñas capaces de degradar os sinais de comunicación bacteriana máis comúns -as Acil-homoserín-lactonas- que poderían ser utilizadas para o tratamento e prevención de enfermidades bacterianas no campo da acuicultura, ademais doutras aplicacións biotecnolóxicas. Chegaríase así a un mecanismo alternativo aos antibióticos co que tratar infeccións ou en conxunción con estes para facelos máis efectivos. O descubrimento é o resultado dun proxecto de investigación financiado pola Xunta de Galicia entre 2006 e 2009 que forma parte da tese de doutoramento ‘Interceptación de señales de comunicación bacteriana tipo N-acilhomoserín lactona (AHL) en bacterias aisladas del medio marino’ do investigador Manuel Romero Bernárdez dirixida pola profesora da Facultade de Bioloxía Ana Otero Casal. Sen resistencias Moitas bacterias patóxenas coordinan o seu ataque comunicándose entre elas mediante a produción de pequenas moléculas sinal nun proceso denominado ‘detección de quórum’ (quorum sensing). Cando estes sinais son eliminados do medio os patóxenos desorganízanse, perden a súa virulencia e polo tanto é moito máis fácil para o sistema inmune destruílos. Esta inhibición dos procesos de comunicación bacteriana, que constitúe unha nova estratexia de loita contra as bacterias infecciosas –‘interceptación de quórum’ (quorum quenching)- representa unha interesante alternativa ao uso de antibióticos, xa que non xera resistencias. Ademais dunha posible aplicación no tratamento de infeccións humanas, son de especial relevancia para tratar as enfermidades das principais especies de peixes producidas en Galicia xa que moitas das bacterias patóxenas que afectan ás instalacións de acuicultura que desenvolveron resistencias ao tratamento con antibióticos se coordinan mediante este mecanismo de comunicación. Dúas patentes Conseguíronse identificar un total de vinte cepas con elevada actividade, das que dúas foron patentadas pola USC co patrocinio da fundación Genoma España. Actualmente o grupo de investigación está centrando os seus esforzos en clonar os xenes responsables desta actividade para ampliar o abanico de aplicacións biotecnolóxicas destas cepas. Os resultados obtidos poñen de relevancia a importancia dos procesos de comunicación bacteriana nos océanos, “confirmándoos como unha fonte incalculable de novas actividades microbianas con potencial biotecnolóxico”, apunta Ana Otero.


